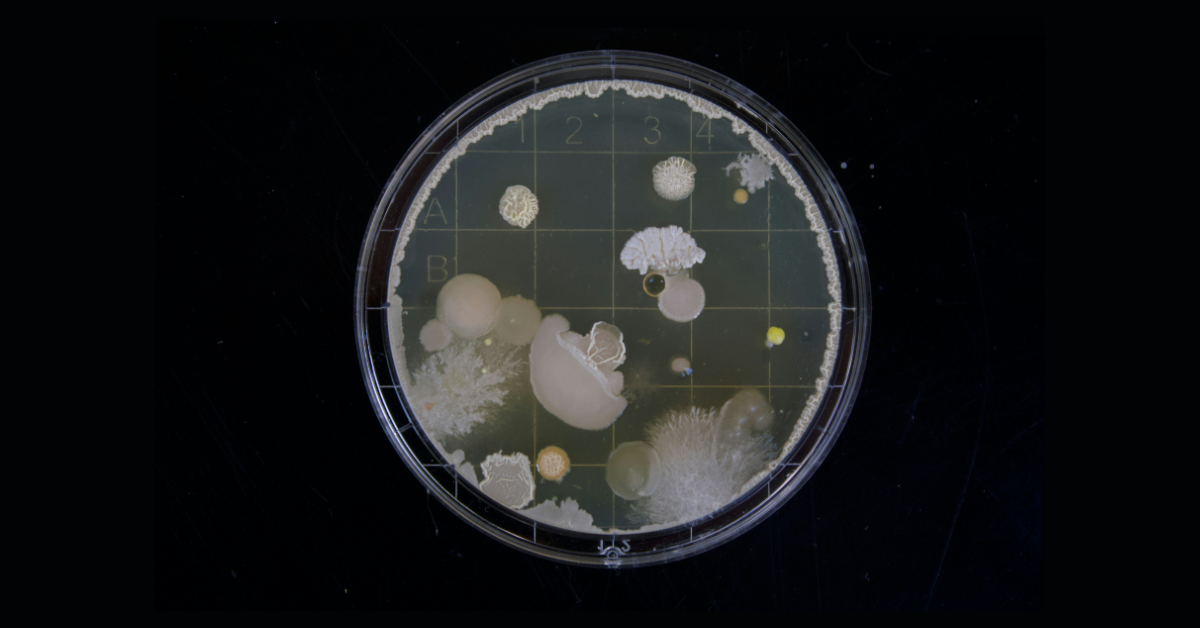

Is Mold Hiding in Your Drinks? Here's What Happens If You Accidentally Drink It
Consuming mold through a drink can cause a few reactions.
Published Oct. 7 2025, 2:11 p.m. ET

You may already be aware that breathing in mold can have a negative effect on your health. In fact, breathing in mold spores has been blamed for everything from skin rashes to nosebleeds. However, people may not be quite as familiar with the effects of mold on the body when ingested, like when you eat or drink it, prompting many to wonder what happens when you drink mold.
While consuming a moldy beverage may seem more unlikely than, say, eating a piece of bread with a bit of mold, it does happen.
That's because some drinks can become moldy without you even realizing, like some juices that are served in containers that you can't see inside of, or if water inside of a bottle or glass becomes moldy thanks to microscopic bits of organic materials that begin to break down.
Wondering what happens when the last beverage you just sipped has some mold in it? Keep reading as we explain what will happen to your body, and what you you can do to figure out whether your water has mold in it.
What happens when you drink mold?
Like we said, accidentally consuming a beverage that contains mold can happen for a variety of reasons, which is why it's important to always thoroughly clean your drinking glasses and water bottles between each use.
As for what happens to your body when a little mold sneaks into your drink, fortunately, the symptoms are typically pretty mild. According to the Jenkins Environmental blog, consuming mold through a drink can cause the following reactions:
- Skin rash
- Headaches
- Vomiting
- Nausea
- Diarrhea
In rare cases, the Cleveland Clinic says that drinking mold can cause certain infections. This includes black mold, which is also known for causing more severe reactions for those who breathe it in.
Of course, those who are allergic to mold or who have underlying health conditions may experience more severe symptoms when they drink moldy beverages. Since preventing mold exposure is the easiest way to avoid it, Jenkins Environmental suggests practicing good hygiene habits to prevent cross-contamination and ensuring that your food is cooked to the appropriate temperature.
Additionally, you should toss or compost any food with visible signs of mold.

How do you find out if there is mold growing in your water bottle?
These days, almost everyone carries around a water bottle to stay hydrated. If you're worried that there may be more than H2O lurking inside your favorite bottle or tumbler, the Cleveland Clinic says there are a few ways you can identify possible mold contamination.
First, it says you can look for visible signs of mold, which may look green, white, or black, and could appear fuzzy or slimy. Additionally, the water itself may have a cloudy appearance.
If your bottle has a funky smell — the Cleveland Clinic describes the smell as being earthy or musty — that's another indicator. The last sign is one that you'll likely find out the hard way, and it involves a bad taste or texture.
If your water has an unusual taste, mold may be to blame.